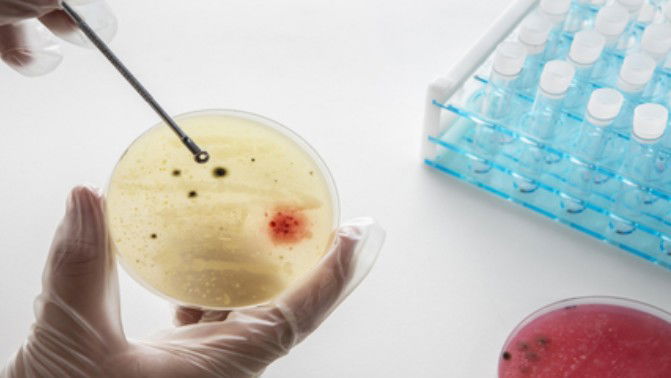

Health
Targeted steroid use shows promise against TB
New Delhi, Oct 11
Treating patients with steroids may offer a universal complementary treatment to fight tuberculosis (TB) -- affecting more than 10 million people annually worldwide, according to a study.
The study published in the journal Scientific Reports showed that targeted use of steroids enhances the function of the immune cells called macrophages to kill the mycobacteria, while diminishing pathways of inflammatory damage.
While steroids like dexamethasone are used in certain TB cases (e.g., TB meningitis), their impact on immune cells is not well understood.
Dexamethasone, a potent glucocorticoid, reduces glycolysis in human lung and blood-derived macrophages. This reduces the amount of energy available in the cell.
The study showed that dexamethasone also reduced the production of both pro- and anti-inflammatory cytokines measured in the study. Although helpful for immunity, limiting the production can also limit damage from excessive inflammation.
"In clinical practice, steroids are the most underused adjunctive therapy for TB. We often rely on steroids to manage inflammation in tuberculosis, particularly in severe forms like TB meningitis,” said Prof Joseph Keane, Professor of Medicine, Trinity College Dublin in Ireland.
"What's reassuring from this study is that dexamethasone not only tempers inflammation but also appears to support the macrophage's ability to control infection. This study provides new evidence to help us redefine steroid use in TB care -- targeting inflammation without compromising antimicrobial defense," he added.
The researchers studied macrophages derived from the blood of healthy volunteers or isolated from lung fluid donated by patients undergoing routine bronchoscopies.
By treating and infecting these macrophages in the lab with Mtb, the scientists could examine and understand how dexamethasone affects the immune response that protects the lungs during infection.
Mtb-infected macrophages have increased survival when they are treated with dexamethasone. This suggests that dexamethasone may protect macrophages from dying due to the harmful effects of infection or detrimental immune responses to infection.
Dexamethasone also reduces bacterial burden in infected macrophages, and the team identified that this is at least partly mediated by autophagy and phagosomal acidification. Dexamethasone can enhance the macrophages' ability to degrade and clear bacteria, helping to overcome infection with Mtb.
The findings support the use of steroids as an extra therapy in conjunction with existing antimicrobial therapies in TB treatment, especially in cases with excessive inflammation.












